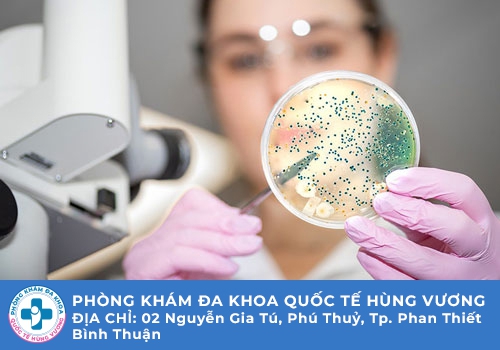

Công ty TNHH MTV dịch vụ y tế Quốc Tế Hùng Vương
4 Nguyễn Gia Tú, Phú Thuỷ, Thành phố Phan Thiết, Bình Thuận
Liên lạc: 0252.7303.888
Từ lâu, bệnh lậu đã được mọi người truyền tai nhau là căn bệnh nguy hiểm có khả năng lây nhiễm nhanh chóng từ người bệnh qua người lành thông qua nhiều con đường khác nhau. Mặc dù là căn bệnh có tác động tiêu cực đến sức khỏe và có thể gây tử vong nhưng chưa nhiều người nắm rõ những kiến thức cơ bản về căn bệnh này. Nhiều người vẫn không biết nguyên nhân bệnh lậu xuất phát là do đâu? Căn bệnh này có mức độ nguy hiểm như thế nào? Hãy cùng làm rõ những kiến thức cơ bản về bệnh lậu thông qua chia sẻ chi tiết bên dưới.
Bệnh lậu được biết đến là căn bệnh lây truyền cực kỳ nguy hiểm với tác nhân gây bệnh là vi khuẩn lậu cầu, khoa học gọi là Neisseria gonorrhoeae. Loại vi khuẩn này tồn tại và có khả năng phát triển ở những vị trí như đường niệu đạo của nam giới, âm đạo của phụ nữ, cổ tử cung, hậu môn, mắt hay miệng.
Vi khuẩn gây bệnh lậu xâm nhập vào cơ thể ban đầu thường không gây ra triệu chứng rõ ràng để phát hiện. Mầm bệnh sẽ phát triển một cách âm thầm và nữ giới thông thường sẽ xuất hiện cảm giác đau tại vùng bụng dưới, đi tiểu sẽ thấy đau buốt và ở miệng có thể xuất hiện tình trạng viêm loét. Nghiêm trọng hơn thì vùng niệu đạo còn có thể xuất hiện máu hay mủ chảy ra với mùi hôi tanh rất khó chịu. Nhiều trường hợp còn nhầm lẫn viêm âm đạo với bệnh lậu dẫn đến tâm lý hoang mang.
Như đã chia sẻ ở trên thì bệnh lậu là căn bệnh có khả năng lây nhiễm thông qua nhiều con đường khác nhau. Và dưới đây là một số nguyên nhân bệnh lậu lây nhiễm:
Nguyên nhân phổ biến hàng đầu khiến nhiều người mắc bệnh lậu là do có các hoạt động quan hệ tình dục không an toàn làm lây nhiễm bệnh. Đặc biệt là nhóm đối tượng có quan hệ thường xuyên với gái mại dâm, quan hệ với nhiều người, không có biện pháp bảo vệ an toàn thì rất dễ lây nhiễm vi khuẩn lậu.
Vi khuẩn lậu hoàn toàn có thể xâm nhập vào trong cơ thể người khỏe mạnh qua những con đường khác nhau như hậu môn, đường miệng hay qua cơ quan sinh dục. Chính điều này là yếu tố khiến cho nam và nữ giới ở trong độ tuổi sinh sản sẽ có tỉ lệ mắc bệnh lậu cao.

Nguyên nhân bệnh lậu lây nhiễm còn có thể thông qua việc nhiễm từ mẹ sang con ở quá trình mang thai. Khi trẻ sơ sinh được sinh ra sẽ có thể thấy trên cơ thể có vết loét do vi khuẩn lậu cầu. Nghiêm trọng hơn thì tình trạng này có thể dẫn đến nhiễm trùng máu, gây tổn thương cho cơ thể. Nếu không chữa trị kịp thời thì vậy lậu cũng có nguy cơ dẫn đến tử vong.
Máu của người bệnh sẽ luôn chứa vi khuẩn lậu cầu nên khi người khỏe mạnh bỗng vô tình tiếp xúc với máu của người bệnh thì sẽ dễ lây nhiễm. Thông thường thì con đường bệnh lậu lây nhiễm như vậy thường là do nghiện ma túy có sử dụng chung bơm kim tiêm.
Tìm hiểu về nguyên nhân bệnh lậu chắc chắn bạn cũng không được bỏ qua những kiến thức về phương pháp hỗ trợ điều trị căn bệnh nguy hiểm này. Căn bệnh này sẽ được hỗ trợ điều trị hiệu quả nếu như người bệnh sớm phát hiện chính xác và có phương án hỗ trợ điều trị phù hợp. Tại các cơ sở chuyên khoa hiện nay đang áp dụng hai phương pháp hỗ trợ chữa trị bệnh lậu như sau:
Đây là phương pháp truyền thống được lựa chọn với ưu điểm tiện lợi, nhanh chóng và giảm bớt chi phí cho người bệnh. Thông thường phương pháp sẽ được áp dụng với trường hợp bệnh nhân mắc bệnh lậu trong giai đoạn đầu khi các triệu chứng còn nhẹ. Nhưng bệnh nhân phải kiên trì sử dụng thuốc thì mới đạt được hiệu quả như mong muốn. Thuốc hỗ trợ điều trị có thể ở dạng kháng sinh tiêm hoặc uống và bệnh nhân đang điều trị phải tuân theo chỉ định của bác sĩ để không dẫn đến tình trạng kháng thuốc.
Phương pháp này được các bác sĩ đánh giá có thể hỗ trợ điều trị bệnh lậu hiệu quả. Phương pháp sẽ dựa trên nguyên lý kỹ thuật về nhiệt điện trường và kỹ thuật bức xạ nhiệt để tác động trực tiếp đến vị trí xuất hiện của vi khuẩn lậu chính xác. Đây là phương pháp hỗ trợ điều trị bệnh hiệu quả, ngăn chặn sự phát triển về sau của vi khuẩn lậu cầu. Ngoài ra phương pháp này còn được đánh giá không gây ra sự đau đớn cho người bệnh không có tác dụng phụ, hồi phục nhanh chóng, giúp tiết kiệm được chi phí.
Và để áp dụng được các phương pháp hỗ trợ điều trị hiệu quả thì bệnh nhân phải chú ý đến việc lựa chọn cơ sở chuyên khoa. Mặc dù Hiện nay có rất nhiều cơ sở chuyên về bệnh xã hội nhưng bệnh nhân phải chú ý lựa chọn cơ sở uy tín và được bộ y tế cấp phép. Và nếu bạn còn phân vân thì hãy đến với địa chỉ của Phòng Khám Đa Khoa Quốc Tế Hùng Vương địa chỉ tại 4 Nguyễn Gia Tú, Phú Thuỷ, Thành phố Phan Thiết, Bình Thuận . Có sổ này mang đến chất lượng tốt trong việc chẩn đoán và hỗ trợ điều trị các bệnh xã hội như bệnh lậu bởi vì:

► Nơi đây hội tụ được nhiều các bác sĩ là chuyên gia trong lĩnh vực bệnh xã hội với kinh nghiệm thực tiễn hỗ trợ chữa trị nhiều căn bệnh xã hội khác nhau.
► Bệnh nhân không cần lo lắng về quy trình vì sẽ có nhân viên y tế hướng dẫn chi tiết và nhanh chóng.
► Các phương pháp để chẩn đoán bệnh lậu và có phương án hỗ trợ điều trị đều áp dụng bằng máy móc cũng như các thiết bị hiện đại.
► Bác sĩ làm việc ở phòng khám không chỉ hỗ trợ điều trị cho người bệnh mà còn dành thời gian để động viên bệnh nhân về mặt tâm lý.
► Toàn bộ thông tin cá nhân sẽ được phòng khám bảo mật, bạn sẽ được khám chữa bệnh với bác sĩ riêng và trong từng phòng bệnh riêng tư.
► Về chi phí bệnh nhân cũng yên tâm là mức phí phù hợp, được công khai cụ thể từ ban đầu để bệnh nhân có sự lựa chọn cũng như chuẩn bị.
Những thông tin mà chúng tôi đã chia sẻ trên đây mong rằng người bệnh có thể xác định rõ hơn về nguyên nhân bệnh lậu lây nhiễm và chủ động trong việc phát hiện bệnh để có phương án hỗ trợ điều trị hiệu quả. Bệnh lậu càng để lâu càng tiến triển nguy hiểm ảnh hưởng nghiêm trọng đến sức khỏe của bạn. Khi bạn chưa thể đến trực tiếp phòng khám mà cần hỗ trợ ngay thì hãy liên lạc tới số 0252.7303.888 hoặc cũng có thể click vào khung chat ngay bên dưới gặp tư vấn viên nhé.
Phòng Khám Đa Khoa Quốc Tế Hùng Vương địa chỉ: 4 Nguyễn Gia Tú, Phú Thuỷ, Thành phố Phan Thiết, Bình Thuận
- Đặt lịch hẹn qua số điện thoại: 0252.7303.888 để được đăng ký khám sớm không mất công chờ đợi.
- Đăng ký ngay để nhận tư vấn và dịch vụ ưu đãi: